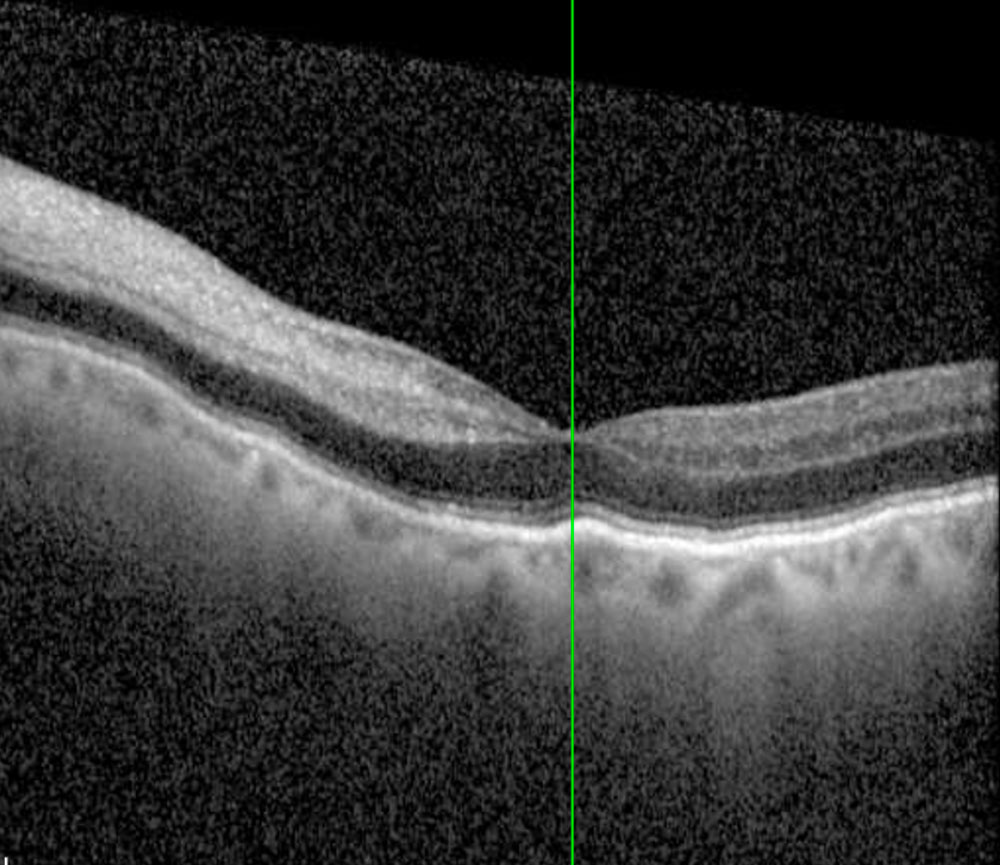

Occlusion artérielle rétinienne (OAR)
Definition
L’occlusion artérielle rétinienne correspond à l’obstruction brutale d’une artère de la rétine, le plus souvent par une embolie d’origine carotidienne ou cardiaque.
C’est l’équivalent d’un accident vasculaire cérébral (AVC) de l’œil.
Informations
SIGNES CLINIQUES
- Baisse brutale, sévère et indolore de la vision d’un œil.
- Scotome central ou perte quasi complète de la vision.
EXAMENS COMPLéMENTAIRES
- Fond d’œil : rétine pâle avec macula rouge cerise.
- OCT : œdème rétinien.
- Bilan cardiovasculaire : doppler carotidien, ECG, recherche de causes emboliques.
PRISE EN CHARGE
- Urgence absolue : traitement dans les premières heures (massage oculaire, diminution de la PIO).
- Prise en charge étiologique en collaboration avec cardiologue et neurologue.
- Pronostic visuel souvent défavorable si le diagnostic est tardif.
complications possibles
- Atrophie optique.
- Perte visuelle irréversible.
quand consulter ?
- Toute baisse brutale et sévère de vision impose une consultation d’urgence.
FAQ – Occlusion artérielle rétinienne
1. Peut-on récupérer la vision après une OAR ?
Rarement, sauf si le traitement est très précoce.
2. Quels examens doivent être réalisés ?
Un bilan cardiovasculaire complet (carotides, cœur).
3. L’OAR est-elle un équivalent d’AVC ?
Oui, elle impose une prise en charge multidisciplinaire rapide.
4. Quels sont les facteurs de risque ?
Athérosclérose, fibrillation auriculaire, hypertension, diabète
5. Peut-elle récidiver ?
Oui, surtout en cas de facteurs non traités.
Vous n’avez pas trouvé la réponse à votre question ?
Utilisez l’espace Commentaires ci-dessous pour poser votre question.
Nous prendrons le temps de vous répondre directement, et votre demande pourra aussi être utile à d’autres patients.

0 commentaires